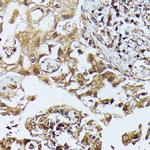
ZIPK Antibody in Immunohistochemistry (Paraffin) (IHC (P))

Search
Invitrogen
ZIPK Polyclonal Antibody
{{$productOrderCtrl.translations['antibody.pdp.commerceCard.promotion.promotions']}}
{{$productOrderCtrl.translations['antibody.pdp.commerceCard.promotion.viewpromo']}}
{{$productOrderCtrl.translations['antibody.pdp.commerceCard.promotion.promocode']}}: {{promo.promoCode}} {{promo.promoTitle}} {{promo.promoDescription}}. {{$productOrderCtrl.translations['antibody.pdp.commerceCard.promotion.learnmore']}}

Please note: We are reviewing Western blot images included in the antibody testing data in our catalog, including those provided by third parties. Unless expressly labeled or annotated as “raw-unedited”, Western blot images included in the antibody testing data in our catalog may have been edited, optimized or otherwise adjusted for presentation.
产品信息
PA5-90193
种属反应
宿主/亚型
分类
类型
抗原
偶联物
形式
浓度
规格
纯化类型
保存液
内含物
保存条件
运输条件
RRID
产品详细信息
Immunogen sequence: MSTFRQEDVE DHYEMGEELG SGQFAIVRKC RQKGTGKEYA AKFIKKRRLS SSRRGVSREE IEREVNILRE IRHPNIITLH DIFENKTDVV LILELVSGGE; Positive Samples: mouse brain, mouse lung, rat brain; Cellular Location: Cytoplasm, Cytoplasm, Nucleus
靶标信息
DAPK3 is a serine/threonine kinase which is functionally linked to cell motility, smooth muscle contractility and cell death processes. DAPK3 is encoded by ZIPK and is a component of desmosomes and of the epidermal cornified envelope in keratinocytes. The N-terminal domain of this protein interacts with the plasma membrane and its C-terminus interacts with intermediate filaments. Through its rod domain, this protein forms complexes with envoplakin. This protein may serve as a link between the cornified envelope and desmosomes as well as intermediate filaments. AKT1/PKB, a protein kinase mediating a variety of cell growth and survival signaling processes, is reported to interact with this protein, suggesting a possible role for this protein as a localization signal in AKT1-mediated signaling.
⚠WARNING: This product can expose you to chemicals including mercury, which is known to the State of California to cause birth defects or other reproductive harm. For more information go to www.P65Warnings.ca.gov.
仅用于科研。不用于诊断过程。未经明确授权不得转售。
篇参考文献 (0)
生物信息学
蛋白别名: DAP kinase 3; DAP-like kinase; DAP3K; death-associated kinase 3; Death-associated like kinase; Death-associated protein kinase 3; Dlk; MYPT1 kinase; unnamed protein product; ZIP kinase; ZIP kinase isoform; ZIP-kinase; Zipper-interacting protein kinase
基因别名: DAPK3; Dapkl; DLK; ZIP; ZIPK
UniProt ID: (Rat) O88764, (Mouse) O54784
Entrez Gene ID: (Human) 1613, (Rat) 64391, (Mouse) 13144




